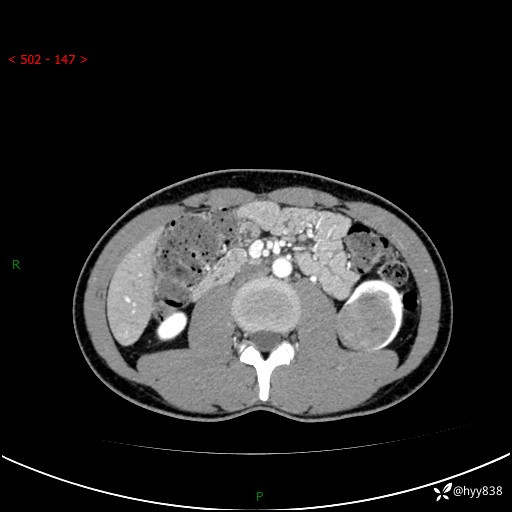
img

年轻男性,发现左肾占位1天。“非好病例”我不发,误诊率高---(有结果)


病例信息
性别:男
年龄:34岁
主诉:发现左肾占位1天
现病史:患者昨日中午进食后出现明显腹痛,腹泻,在我院急诊科行补液及对症治疗,双肾输尿管彩超提示左肾占位(5.2*4.3cm),平素无明显腰痛,无再发肉眼血尿等情况,现为求处理左肾占位,遂来我院,门诊以左肾占位收治入院。 患者起病以来,精神、食欲、睡眠尚可,大便可,小便如上,体力体重无明显下降。
双肾CT平扫+增强(三期)

最后编辑于 2024-05-14 · 浏览 1724